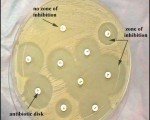

Antibiotic Sensitivity Test by Kirby-Bauer method
The Kirby-Bauer disk diffusion test is a standardized protocol for determining antibiotic susceptibility.
A pure culture of the test organism is inoculated on Mueller-Hinton agar.
Paper ...
